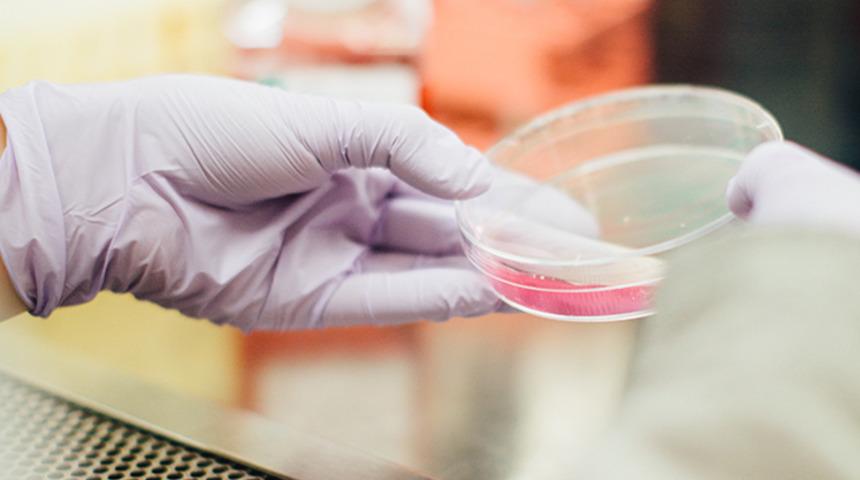
ABD'li bilim insanlarından umut veren koronavir&uuml;s testi!

Koronavirüs ile mücadele tam gaz devam ediyor. Bazı uzmanlar mücadelede kontrolü sağlamak için test sayısını arttırılmasından yana. Fakat koronavirüs için geliştirilen test kitlerinin süreleri oldukça uzun. Bu da hastalara da koronavirüs tanısı konulması sürecini geciktiriyor. Hal böyle olunca dünyanın dört bir yanından bilim insanları kollarını sıvadı ve kısa sürede tanı koyabilecek bir test kiti geliştirmek için çalışmalara başladı. Bu çalışmaların bir meyvesi, Utah'ta ortaya çıktı.
ABD'nin Utah eyaletinde faaliyetlerini sürdüren bilim insanları, yeni kısa sürede sonuç veren bir test kiti geliştirmeyi başardı. Bilim insanlarının iddialarına göre geliştiren kit sadece 60 saniye içerisinde kişinin koronavirüslü olup olmadığını belirleyebiliyor. Üstelik test kiti tüm bunları yaparken, hepimizin gözü önünde olan bir teknolojiyi kullanıyor; Bluetooth teknolojisini.
Bilim insanlarının açıklamalarına göre test kiti, Bluetooth yardımı ile akıllı telefonlara bağlanıyor. Yani test oldukça da teknolojik. Akıllı telefon ile iletişim kuran test kiti, bünyesinde bir sensör bulunduruyor. Bu sensör, koronavirüsün tespit edilmesini sağlayacak DNA zincirlerine karşı duyarlı bir hale getirilmiş. Kişi hapşurduğunda veya öksürdüğünde, var olan koronavirüs sensöre yapışıyor ve sensörün elektriksel direnci değişiyor. Bu değişim sonucu sensör virüsü algılıyor. Algıladığı verileri bluetooth aracılığıyla akıllı telefona gönderen test kiti, bir rapor hazırlıyor ve kişide koronavirüs olup olmadığını ortaya çıkartıyor. Bu zincirleme süreç ne kadar uzun sürüyor gibi görünse de sadece 60 saniyede tamamlanıyor.

Bilim insanları test kiti için bir amaç belirlemiş durumda. Onların amacı testin seri üretime geçip olabildiğince yaygınlaşması. Bu anlamdaki çalışmalarına ise aynı tempoda devam ediyorlar.